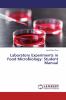
Laboratory Experiments in Food Microbiology: Student Manual

English
Paperback
₹3506
(All inclusive*)
Delivery Options
Please enter pincode to check delivery time.
*COD & Shipping Charges may apply on certain items.
Review final details at checkout.
Looking to place a bulk order? SUBMIT DETAILS
About The Book
Description
Author
This practical book included some applicable science experiments for food microbiology. It guides the students to 12 experiments cover a brief overview of some of the major focus of food microbiology. The overall topics covered in this book including factors affect the microbial growth milk fermentation and bacterial growth curve food spoilage in fruits and vegetables and milk food preservation methods microbiology of water and isolation and identification of pathogenic bacteria from meat products. This book also provides opportunities for students to manual handling practices. All assays can be easily applying to large and small group teaching.
Delivery Options
Please enter pincode to check delivery time.
*COD & Shipping Charges may apply on certain items.
Review final details at checkout.
Details
ISBN 13
9783659849664
Publication Date
-11-02-2016
Pages
-68
Weight
-101 grams
Dimensions
-150x220x4.09 mm